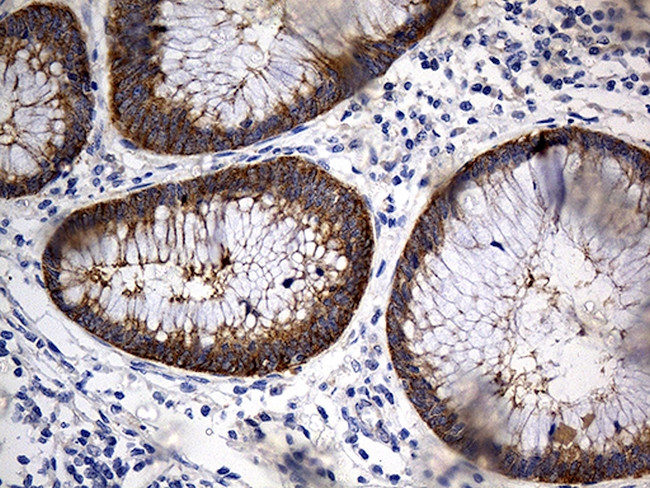
TRIM29 Antibody in Immunohistochemistry (Paraffin) (IHC (P))

Search
OriGene
TRIM29 Monoclonal Antibody (OTI5C11), TrueMAB™
{{$productOrderCtrl.translations['antibody.pdp.commerceCard.promotion.promotions']}}
{{$productOrderCtrl.translations['antibody.pdp.commerceCard.promotion.viewpromo']}}
{{$productOrderCtrl.translations['antibody.pdp.commerceCard.promotion.promocode']}}: {{promo.promoCode}} {{promo.promoTitle}} {{promo.promoDescription}}. {{$productOrderCtrl.translations['antibody.pdp.commerceCard.promotion.learnmore']}}
产品信息
TA812274
种属反应
宿主/亚型
分类
类型
克隆号
抗原
偶联物
形式
浓度
规格
纯化类型
保存液
内含物
保存条件
运输条件
靶标信息
The protein encoded by this gene belongs to the TRIM protein family. It has multiple zinc finger motifs and a leucine zipper motif. It has been proposed to form homo- or heterodimers which are involved in nucleic acid binding. Thus, it may act as a transcriptional regulatory factor involved in carcinogenesis and/or differentiation. It may also function in the suppression of radiosensitivity since it is associated with ataxia telangiectasia phenotype.
仅用于科研。不用于诊断过程。未经明确授权不得转售。
篇参考文献 (0)
生物信息学
蛋白别名: Ataxia telangiectasia group D-associated protein; ataxia-telangiectasia group D-associated protein; FLJ36085; tripartite motif protein TRIM29; Tripartite motif-containing protein 29; unnamed protein product
基因别名: ATDC; TRIM29
UniProt ID: (Human) Q14134
Entrez Gene ID: (Human) 23650